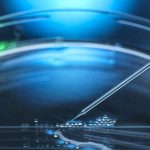

[ad_1]
You have possibly discovered advertisements for these “superfood powders” scattered throughout social media or on your preferred podcast.
Athletic Greens, Every day Greens, Supergreens — mix just just one scoop of these multivitamin powders into a glass of h2o or a shake, their advertising commonly suggests, and you can get all of the vitamins and minerals you want for the working day, as effectively as added health positive aspects like a more robust immune procedure, a lot less anxiety, much better digestion and far more energy.
These “greens powders” or “superfood powders,” as they are in some cases known as, normally host a hodgepodge of nutritional vitamins and minerals, as nicely as other stylish elements like probiotics, ground up kale, chia seeds and ashwagandha.
But are they really a shortcut to better wellness?
“They’re so attractive,” claimed Dr. Marion Nestle, an emeritus professor of diet, food stuff research and community wellness at New York College. “You believe, ‘Oh, this will be so simple.’”
But as with most points nourishment-related, you’ll possible need far more than a scoop of powder to strengthen your general perfectly-staying, she reported.
What’s in them?
The ingredients lists on websites and packaging for the powders can examine like a phrase salad of wellness buzzwords.
You’ll typically come across the standard slate of natural vitamins and minerals, like nutritional vitamins E and C (which are antioxidants), biotin (or vitamin B7, which allows you metabolize food) and vitamin B12 (which is necessary for blood and nerve cell wellbeing).
Several “superfood powders” also comprise plant proteins (like pea protein or brown rice protein powder) floor up fruits and vegetables like broccoli, spinach and kale and supplemental probiotics (intestine-friendly microbes) and prebiotics (which act as foods for the probiotics).
You might also obtain a cluster of plant substances — together with ashwagandha, reishi, ginseng and rhodiola, which are called adaptogens and are purported to assistance with a array of ills, which includes worry reduction and electricity output — and dandelion root, rose hip and milk thistle seed extract.
“This is like throwing the kitchen area sink into a powder,” reported Dr. Pieter Cohen, an affiliate professor at Harvard Medical Faculty who experiments supplements.
Will these powders make me much healthier?
If you’re already following a fairly balanced diet and aren’t deficient in any natural vitamins or minerals, you most likely never want to choose multivitamin health supplements like these, the gurus explained.
“Superfood powders” generally comprise far more than the each day recommended quantities of several natural vitamins and minerals — one serving of AG1, the powder created by Athletic Greens, for example, supplies a lot more than 550 % of the daily proposed amount of vitamin E, and 1,100 percent of the day by day advisable sum of biotin.
For the most part, your system can handle these surplus nutrients, explained Dr. Gerard Mullin, an affiliate professor at Johns Hopkins Medicine who specializes in gastroenterology. Your kidneys will crack down and dispose of most of them, he mentioned. But selected nutritional vitamins, like nutritional vitamins A, D, E and K, can result in destructive effects if they arrive at substantial enough levels, he included — nevertheless this is rare.
As for supplemental probiotics, there isn’t crystal clear evidence that by now healthy folks will grow to be healthier by using them regularly, Dr. Nestle stated. And prebiotic dietary supplements may well stimulate common bowel actions and market gut health and fitness, she added, but similarly, the science on their requirement for most men and women is significantly from settled.
A lot of adaptogens like ashwagandha and ginseng have been applied for hundreds of years in Jap medicine, in component for their purported tension-relieving homes. But substantial-high quality proof on no matter if they can do items like stabilize your temper or ease anxiety is missing, Dr. Cohen reported.
“There have been no clinical trials displaying how efficient they are, just infomercials,” Dr. Mullin extra.
Representatives from Athletic Greens and Huel (which can make the Day by day Greens mix) stated that although some scientific reports have found inbound links concerning the personal substances in their merchandise and sure health and fitness gains, no arduous, impartial reports have evaluated the health added benefits of the goods themselves.
When companies grind veggies like broccoli or spinach down into supplements or powders, some of the vitamins and other effective factors are missing in the system, Dr. Nestle stated, like some of their fiber, which is necessary for regulating digestion and keeping your gut healthier.
You are superior off acquiring vitamins from taking in entire, unprocessed food items right, Dr. Mullin reported.
And several of these powders can arrive with a significant price tag tag — a 30-serving supply from Athletic Greens commences at $79, although Huel’s Everyday Greens edition costs $45, and Enso Superfoods’ Supergreens powder fees $59.99.
“Why not just try to eat some spinach?” Dr. Nestle said. “I don’t very get it.”
The bottom line
As with all nutritional supplements, the Foods and Drug Administration has not evaluated these greens powders for basic safety or efficacy, so you cannot be confident that what is outlined on the label is what’s in the package.
When getting nutritional supplements, it’s essential to appear for seals from dependable third-social gathering certification programs, like the U.S. Pharmacopeia or NSF, on their labels, Dr. Cohen reported, which ensures component quality.
Authorities say that these powders probably don’t pose a significant hazard to the average man or woman, but they also could not do substantially superior.
“You want to acquire them, get them,” Dr. Nestle reported. “But it’s not heading to resolve dietary difficulties.”
[ad_2]
Source backlink